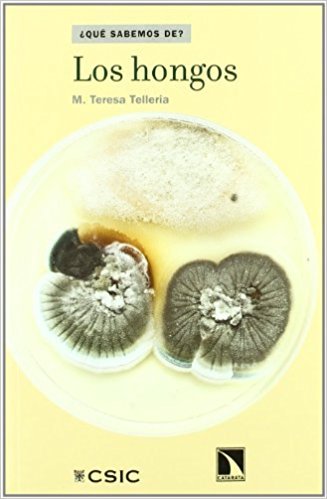
https://sites.google.com/site/medicinaevolucionista/seminarios-2017-1/hongos/resumen-post/41eKP8TqRkL._SX325_BO1,204,203,200_.jpg

Resumen del seminario Hongos y su potencial pro-inflamatorio Autores: Alvaro Daschner y José-Luis Gómez Pérez María Teresa Telleria, Profesora de Investigación del Real Jardín Botánico de Madrid (CSIC), ofreció al público una excelente introducción al reino de los hongos, dividiendo su presentación en tres bloques que caracterizan la falta de conocimiento del público general en esta materia, a saber, la DESUBICACIÓN, la DIVERSIDAD y el DESCONOCIMIENTO. Explicó a través de la historia de los repetidos cambios del árbol de la vida la condición de desubicación de los hongos, dio una descripción somera de los grandes grupos donde se pudo apreciar la gran diversidad que existe, pudiéndolos encontrar tanto en entornos extremos como aquellos decisivos en el ciclo del fósforo del 75% de las plantas, o los utilizados en la gastronomía. Insistió en el gran desconocimiento de este grupo tan polifilético, del que más que en otros reinos u órdenes se sospecha que queda una inmensa proporción de especies por descubrir. A pesar de todo ello, 8 Premios Nobel lo han sido gracias a descubrimientos relacionados con los hongos, como el descubrimiento de antibióticos o conocimientos clave de mecanismos bioquímicos y genéticos de los seres vivos. Sari Arponen, del Servicio de Medicina Interna del Hospital universitario de Torrejón, se encargó de hablar de micotoxinas, centrando su argumentación en la ubicuidad de las mismas en los alimentos. Los organismos de seguridad europea y nacional, la EFSA y la AECOSAN, respectivamente, velan por la seguridad con controles para detectar posibles superaciones de los límites de seguridad establecidos. Sin embargo es muy difícil la valoración de los posibles efectos adversos de la concurrencia de niveles autorizados de varias micotoxinas en la alimentación o incluso con otros factores tóxicos o nocivos , como son los disruptores endocrinos. Además las interacciones de las micotoxinas con la microbiota también influyen en el efecto que éstas pueden tener en el ser humano. Alvaro Daschner, del Servicio de Alergología del Hospital Universitario de la Princesa tuvo la ocasión de presentar un trabajo de hipótesis publicado recientemente en la revista Frontiers in Immunology. En el mismo analiza la relación entre los hongos y el ser humano desde el punto de vista evolutivo. La gran resistencia a la infección invasiva por hongos que caracteriza al hombre y otros mamíferos se explica por la selección evolutiva de rasgos de defensa frente a una exposición ubiquitaria de hongos. Esto a su vez explicaría la gran variabilidad de síntomas, frecuentemente exagerados e inadecuados que se asocian al síndrome de hipersensibilidad a moho y humedad. En los debates se habló de una hipótesis postulada por A. Casadevall, que asociaría la desaparición de los dinosaurios y la emergencia de los mamíferos con los hongos. En este sentido los mamíferos son homeotérmicos, lo que les confiere para la gran proporción de hongos una resistencia natural. Se habló de la gran dificultad del médico para evaluar y tratar adecuadamente a pacientes donde existe sospecha de asociación entre síntomas diversos y exposición a humedad u hongos, sobre todo por falta de biomarcadores de exposición o de enfermedad. Para quién desee informarse más sobre el Reino de los Hongos recomendamos: "Los hongos" (¿Qué sabemos de?) de M. Teresa Telleria |